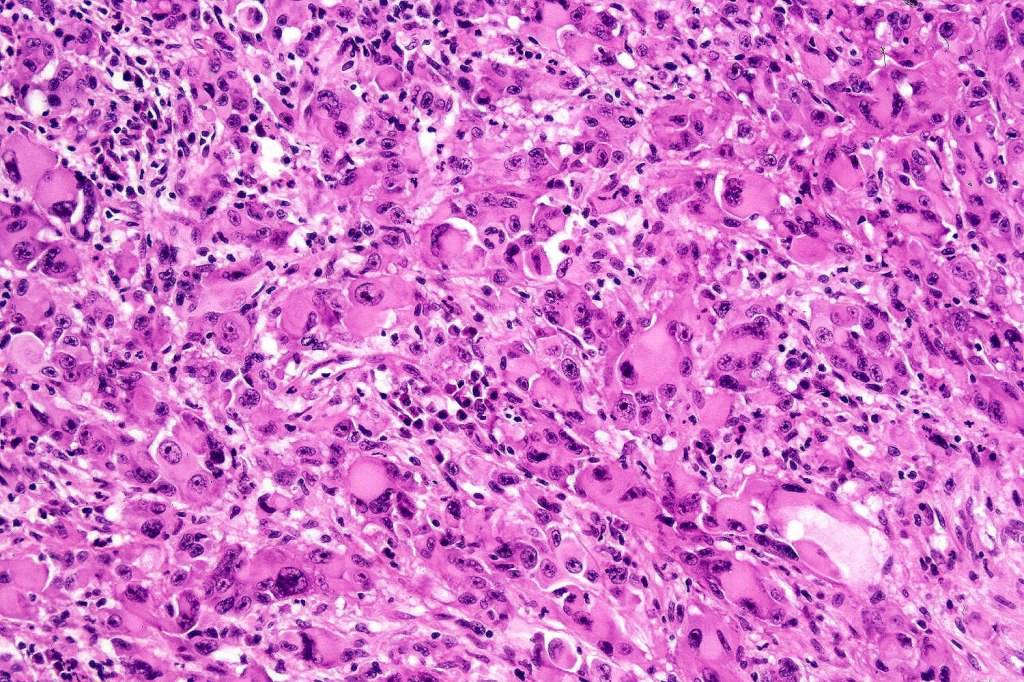
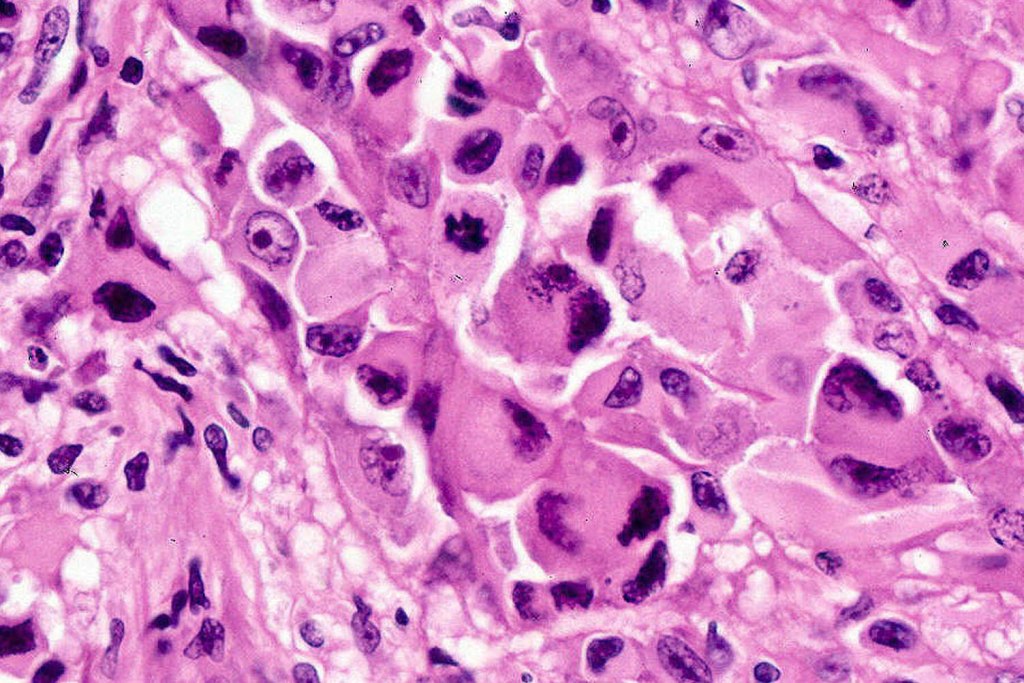
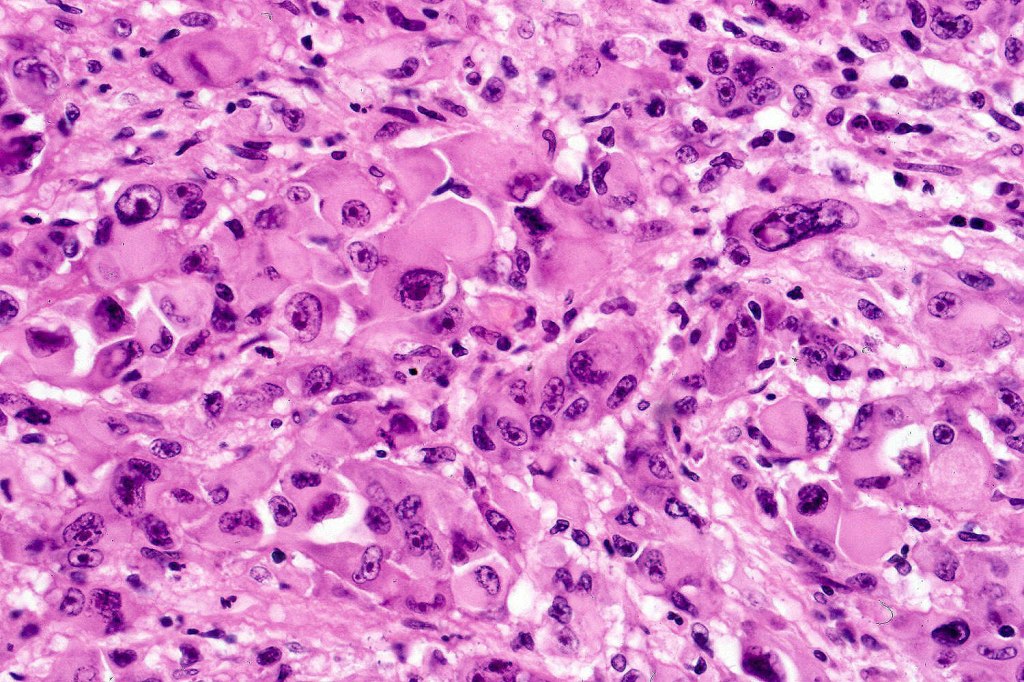
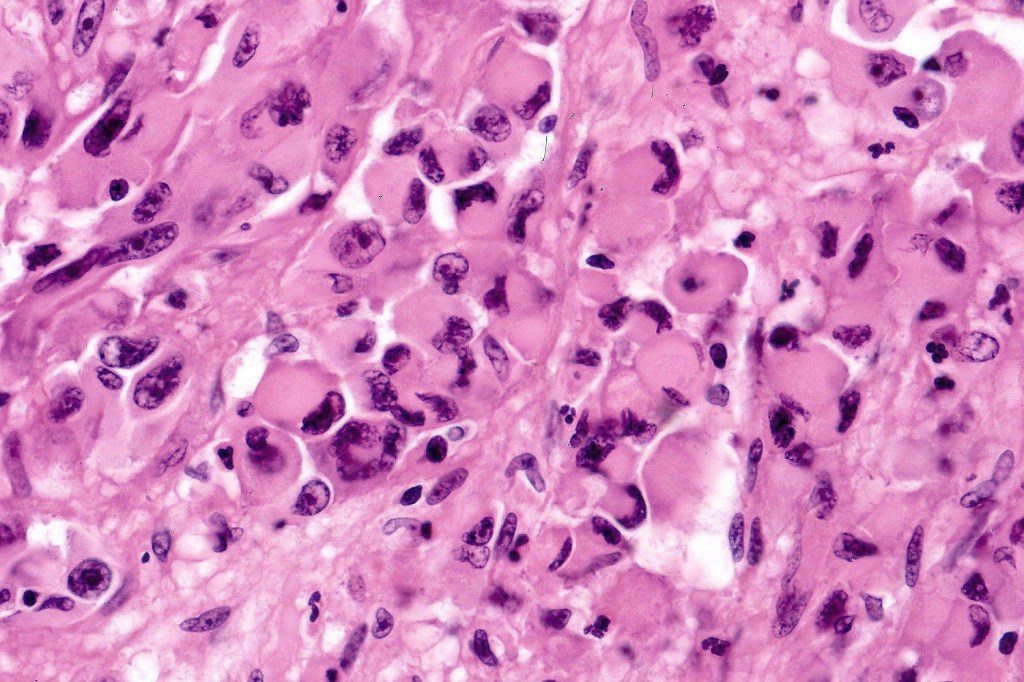
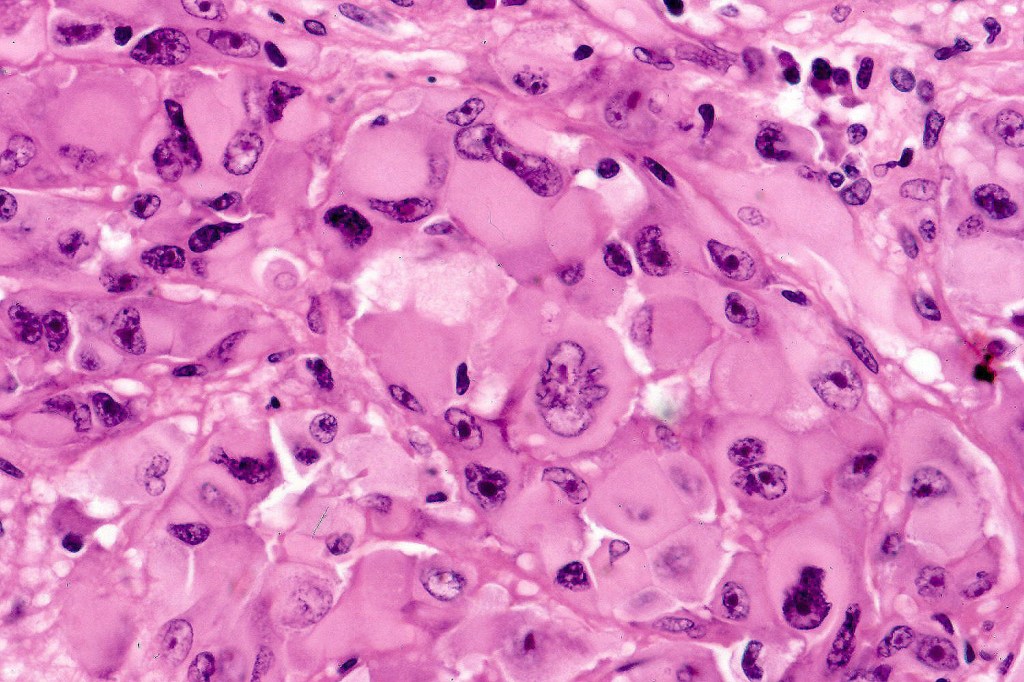
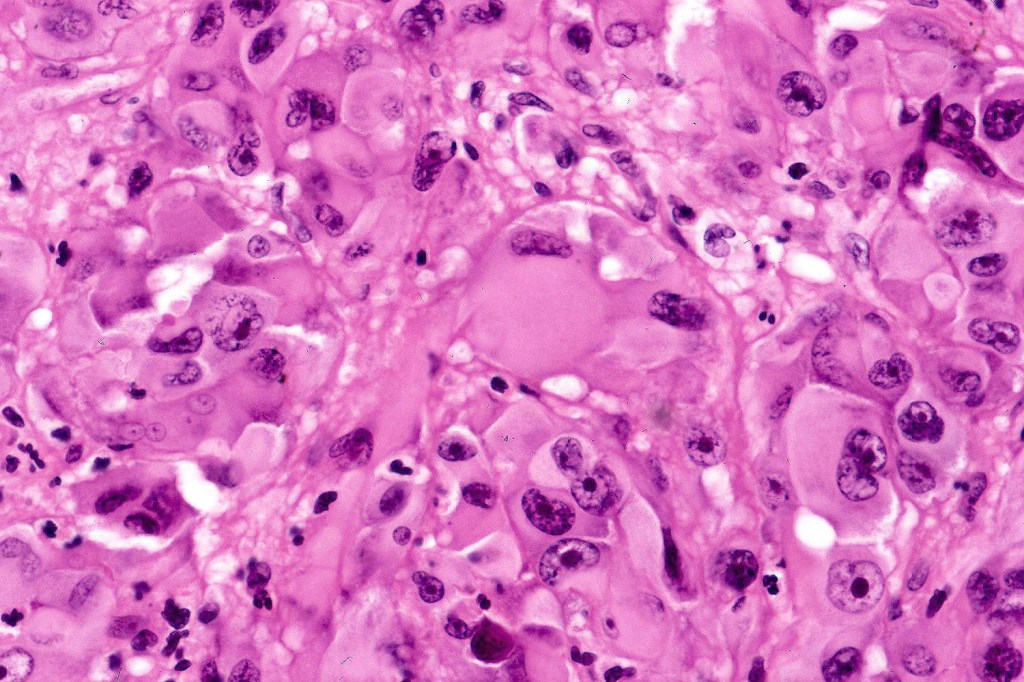
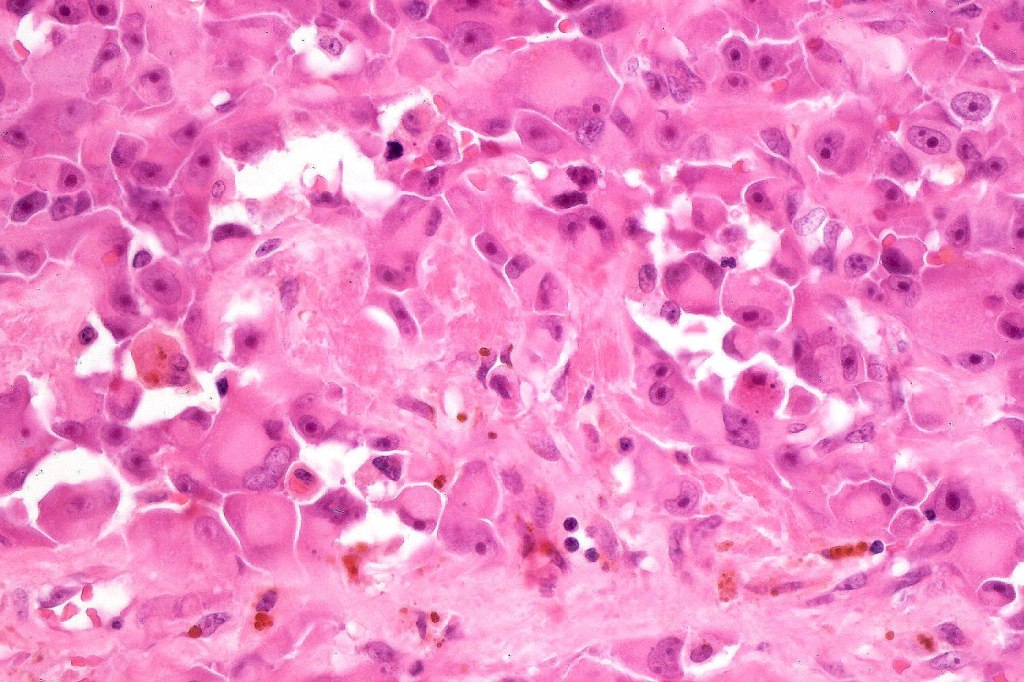
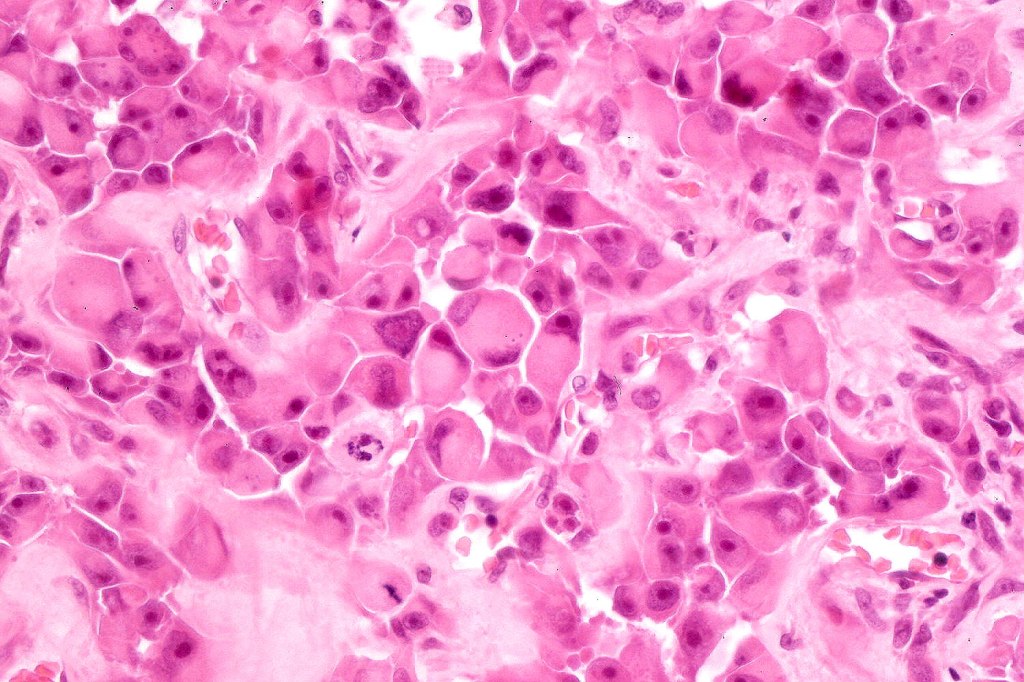
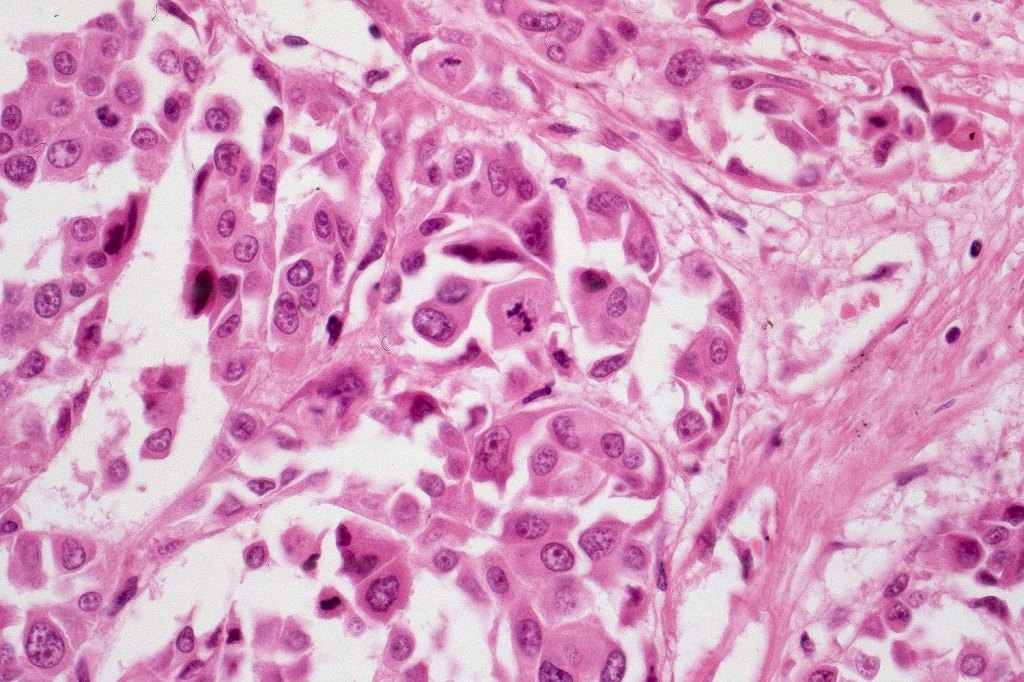

•Extremely rare often amelanotic, high-grade variant (based on the majority of documented cases representing metastases. The biological potential of primary tumors with rhabdoid features is uncertain owing to the paucity of reported cases)
•Metastases & recurrent disease>>primary tumors
•Characterized by pleomorphic tumor cells with large eosinophilic, hyaline globular inclusions and eccentric vesicular nuclei containing prominent nucleoli, mitoses often conspicuous
•Inclusions predominantly composed of vimentin intermediate filaments
•Immunophenotype is variable with possible loss of expression of one or more of the usual melanocytic markers including S100 & SOX10 (occasionally), HMB45/MART-1 (not uncommon), MITF & tyrosinase
•A broad panel is recommended to detect positivity in one or more of these markers
•Loss of INI1 expression described
•Vimentin & sometimes desmin expression positive in the inclusions
•Occasional weak keratin expression reported
•SMA, Desmin, and WT1 expression described in 1 case (abstract below).
•PRAME positivity in 4 cases documented (abstract below)
•Very sparse melanin pigment may be identified
•With metastatic tumor, clinical history can be crucial to establish the correct diagnosis
•Differential diagnosis includes rhabdoid change in renal cell carcinoma, malignant peripheral nerve sheath tumor, synovial sarcoma, extraskeletal myxoid chondrosarcoma, leiomyosarcoma proximal epithelioid sarcoma & rhabodid tumor in infants. There is a superficial resmblance to the inclusions seen in BAP1-inactivated melanocytoma but the frankly malignant nature of the rhabdoid cells, history of a primary tumor in the majority of cases and loss of BAP1 in BAP1-inactivated melanocytoma makes for ready distinction.
All of the cases that I have personally encountered have been metastases.

In this example, rhabdoid change accounted for only a small component of the tumor. IHC is S100

Leave a comment